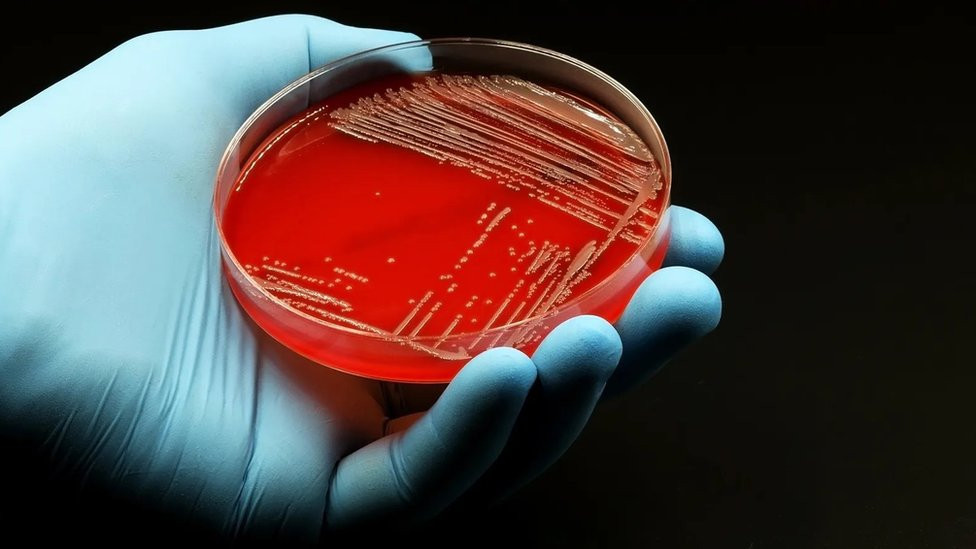
Antibiotici

BBC News
Zdravlje: Da li se antibioticima uništavaju i neophodne bakterije u ljudskim crevima

Getty Images Antibiotici su osnovni sastojak savremene medicine i svake godine spasavaju milione života, ali mogu biti štetni po normalan bakterijski sistem na kojem se zasniva naše zdravlje. Naše telo je domaćin bilionima bakterija bez kojih ne možemo da živimo, a najviše ih je u crevima. Da li mi trajno oštećujemo ovaj vitalni deo našeg […]
Antibiotici su osnovni sastojak savremene medicine i svake godine spasavaju milione života, ali mogu biti štetni po normalan bakterijski sistem na kojem se zasniva naše zdravlje.
Naše telo je domaćin bilionima bakterija bez kojih ne možemo da živimo, a najviše ih je u crevima.
Da li mi trajno oštećujemo ovaj vitalni deo našeg tela svaki put kad uzmemo antibiotik?
„Mikrobiom creva je složena mreža mikrobiotskih životnih oblika i svih stvari koje su neophodne da bi se oni prehranili u različitim delovima tela“, kaže Džejms Kinros, kolorektalni hirurg sa Imperijalnog koledža u Londonu.
Mikrobiom creva igra ogromnu ulogu u održavanju našeg zdravlja, između ostalog reguliše imuno sistem i pomaže pri varenju.
Eksperti tvrde da su antibiotici jedna od najvećih pretnji po mikrobiom naših creva.
- Lekovi koji menjaju našu ličnost
- Superbakterije otporne na antibiotike: Novi neprijatelj beba
- Bakterije otporne na antibiotike ubijaju milione ljudi, pokazala studija
Antibiotici, koji se često prepisuju za lečenje i sprečavanje bakterijskih infekcija, kamen su temeljac moderne medicine.
Ali, prilikom napadanja bakterija koje izazivaju infekcije u našem telu, antibiotici mogu nenamerno da istrebe druge bakterije iz naših tela.
Sve je veća zabrinutost među naučnicima oko zdravstvenih posledica naše sve veće zavisnosti od antibiotika.
Između 2000. i 2015. godine, globalno prepisivanje antibiotika povećalo se za 65 odsto.
Problem sa porastom upotrebe antibiotika je dvostruki: šteta koju prave mikribiomu naših creva i sve veća bakterijska rezistencija na antibiotike.

„Antibiotici narušavaju osetljiv ekosistem mikrobioma naših creva zbog čega su preživele bakterije u većem riziku od doniranja rezistentnih gena patogenima“, kaže Gautam Dantas, profesor laboratorijske i genomske medicine na Medicinskom fakultetu Vašingtonskog univerziteta u Sent Luisu, u SAD.
Mi znamo da što je raznovrsnija bakterijska populacija naših creva, po nas je bolje.
Ali svaka terapija antibioticima narušava njihov broj, zato što antibiotici nisu dovoljno precizno usmereni da ubiju samo patogenske bakterije koje izazivaju infekciju.
Umesto toga, napadaju sve bakterije u našim crevima.
„Javlja se kolateralna šteta.
„Zamislite šumu u kojoj pokušavate da se rešite jedne infestacije korova. Mi koristimo antibiotike tako što vršimo tepih-bombardovanje čitave te šume, ubijajući i dobre i loše bakterije“, kaže Dantas.
Kad su se naučnici retrospektivno pozabavili mikrobiomima, ljudi koji su lečili infekciju antibioticima, otkrili su da se diverzitet mikrobioma uglavnom oporavi u roku od nekoliko meseci, dodaje profesor.
Kod nekih ljudi, pak, neke dobre bakterije se više nikad ponovo ne pojave, napominje.
- „Ne gutajte antibiotike na svoju ruku, neke infekcije su sve žilavije i otpornije na njih“
- Koje ćelije mogu da vam podare superimunitet
- Kako da zaustavimo otpornost bakterija na antibiotike
Dantas i njegov tim istraživača proučavaju uzorke stolice dece lečene u pedijatrijskoj bolnici povezanoj sa laboratorijom.
Uzorci su sakupljani rutinski, pre bilo kakvih antibiotika i infekcija, što je omogućilo njegovom timu da primeti promene kod dece koja dobiju infekcije, a kasnije i antibiotike.
Dantas je koristio ove uzorke da uporedi promene u mikrobiomu creva posle antiobiotika kod dve grupe novorođenčadi: prevremeno rođenih beba, koje su rođene pre 36. nedelje i beba rođenih posle 36. nedelje.
„Ono što znamo da se dešava kod odraslih ljudi posle uzimanja antibiotika još je dramatičnije kod beba: manja gustina mikrobioma i ogromni skokovi gena otpornih na lek“, kaže on.
Iako se posledice razlikuju od čoveka do čoveka i zavise od naših godina, konsenzus među naučnicima jeste da efekti samo jedne terapije antibiotika mogu biti trajni.
„Neki ljudi su veoma podložni oštećenju u mikrobiomu od antibiotika, a ekologija njihovog mikrobioma će se dramatično promeniti i nikad se neće vratiti na ono što je bila pre doze antibiotika.
„Gubimo diverzitet u našim crevima i ključni mikrobi koji su nas održavali stotinama hiljada godina nestaju u do sada neviđenim vremenskim okvirima“, kaže Džejms Kinros.
Naučnici i dalje pokušavaju da shvate koje su dugoročne zdravstvene posledice upotrebe antibiotika po mikrobiome naših creva.

„Mi znamo da antibiotici imaju sposobnost da utiču na svaki domen mikrobiomske funkcije.
„Ne smanjuju broj bakterija, već utiču na ulogu mikroba na složene i individualizovane načine koje ne razumemo baš najbolje“, kaže Kinros.
On dodaje da ne zabrinjava samo njihov uticaj na bakterije u crevima, već i sekundarne posledice razvoja imunog sistema.
Studije pokazuju da uzimanje stalnih doza antibiotika ima kumulativni efekat, a posledice su veće ako uzimate doze šireg spektra.
To se često naziva i „hipotezom više pogodaka“.
„Ovo je neobičan evolutivni eksperiment koji radimo sami sebi svaki put kad uzmemo antibiotik“, kaže Dantas.
Poglejdate kako bakterija mutira i postaje otporna na antibiotik
Druga posledica dugoročne upotrebe antibiotika je rizik od rezistencije.
Kad je bakterijska populacija izložena antibiotiku, oni koji nemaju gene za antibiotsku rezistenciju obično izumru.
Ali oni koji je imaju ili gene pokupljene iz okruženja ili spontanih mutacija preživljavaju.
Na taj način lekovi aktivno biraju bakterije koje su otporne na antibiotike.
To je problem kad pategonske bakterije izvuku korist iz te adaptacije.
„Svaki put kad pijemo antibiotike, povećava se proporcionalni rizik da se mikrobiom creva obogati genima rezistentnim na lekove.
„Kad se sledeći put pojavi parazit, on bi mogao da pokupi neke od tih selektivnih otpornih gena iz creva“, kaže Dantas.
A taj proces se ne odvija samo u našim crevima, kaže Kreg Meklin, profesor evolucije i mikrobiologije sa Univerziteta u Oksfordu.
„Rezistentne bakterije mogu da se presele iz creva u druge delove tela, tako da ono što se dešava u crevima ima uticaja na ostatak tela“, kaže on.

Štetan i spasilački uticaj antiobiotika jedna je od najvećih zagonetki koje muče naučnike iz čitavog sveta.
Iako nema jednog rešenja, ima pristupa koji bi mogli da ublaže štetne posledice antibiotika po naše zdravlje.
„Antibiotici su fantastični lekovi koji su spasili milione života.
„Veoma su dragoceni resursi i treba ih koristiti, ali moramo da pronađemo način kako precizno da ih usmeravamo“, kaže Kinros.
Naučnici se sada bave antibioticima koji više ciljaju određene delove tela, kao i onima koji su usmereni ka konkretnim bakterijama, kaže Meklin, sa idejom da se rešavaju samo bakterija kojih žele da se reše, a da ostave korisne bakterije u crevima netaknute.
Entoni Bakli, vanredni profesor mikrobiologije creva sa Univerziteta u Lidsu, kaže da je najajče oružje kojim trenutno raspoložaemo naša ishrana.
„Ishrana je jedno od najvećih pogonskih goriva koje izgrađuje ljudski mikrobiom“, kaže on.
Istraživačka grupa sa Univerziteta u Lidsu koja se bavi infekcijama povezanim sa zdravstvom analizira posledice antibiotika na mikrobiom poslednje dve decenije.
„Najveća raznovrsnost hrane koju jedemo obično je povezana sa većom raznolikošću mikroba u crevima, a čini se da vlakna posebno deluju pozitivno“, kaže Ines Moura, naučna saradnica sa Fakulteta za medicinu i zdravlje Univerziteta u Lidsu, koja trenutno ispituje posledice različitih hranljivih sastojaka po mikrobiom creva i kako oni mogu da smanje negativne posledice antibiotika.
Vlakna u ishrani posebno su važna zato što ih mikrobi u našem telu vare i proizvode kratkolančane masne kiseline, koje daju energiju ćelijama u omotaču creva, kaže Bakli.
„Kad uzmete antibiotike, broj mikroba koji proizvode kratkolančane masne kiseline se smanji i treba im vremena da se oporave.
„Naša teorija je da, unošenjem vlakana u ishrani, ona pružaju zamenu za te mikrobe na kojem mogu da rastu i proizvode masne kiseline, i uz malo sreće ponovo uspostave ravnotežu“, kaže on.

Ironija u korišćenju antibiotika je da se, sa svakom novom terapijom koju uzmemo, potencijalno smanjuje sposobnost našeg tela da se bori protiv infekcija, a povećava naša zavisnost od antibiotika.
„Mnogo je bolje da ne zavisimo od antibiotika, nego da se usredsredimo na bio-otpornost naše unutrašnje ekologije tako što ćemo jesti zdravo, pogotovo u ranoj fazi života, jer tu antibiotici prave najviše štete“, kaže Kinros.
Pogledajte i ovu priču
Pratite nas na Fejsbuku,Tviteru i Vajberu. Ako imate predlog teme za nas, javite se na [email protected]





